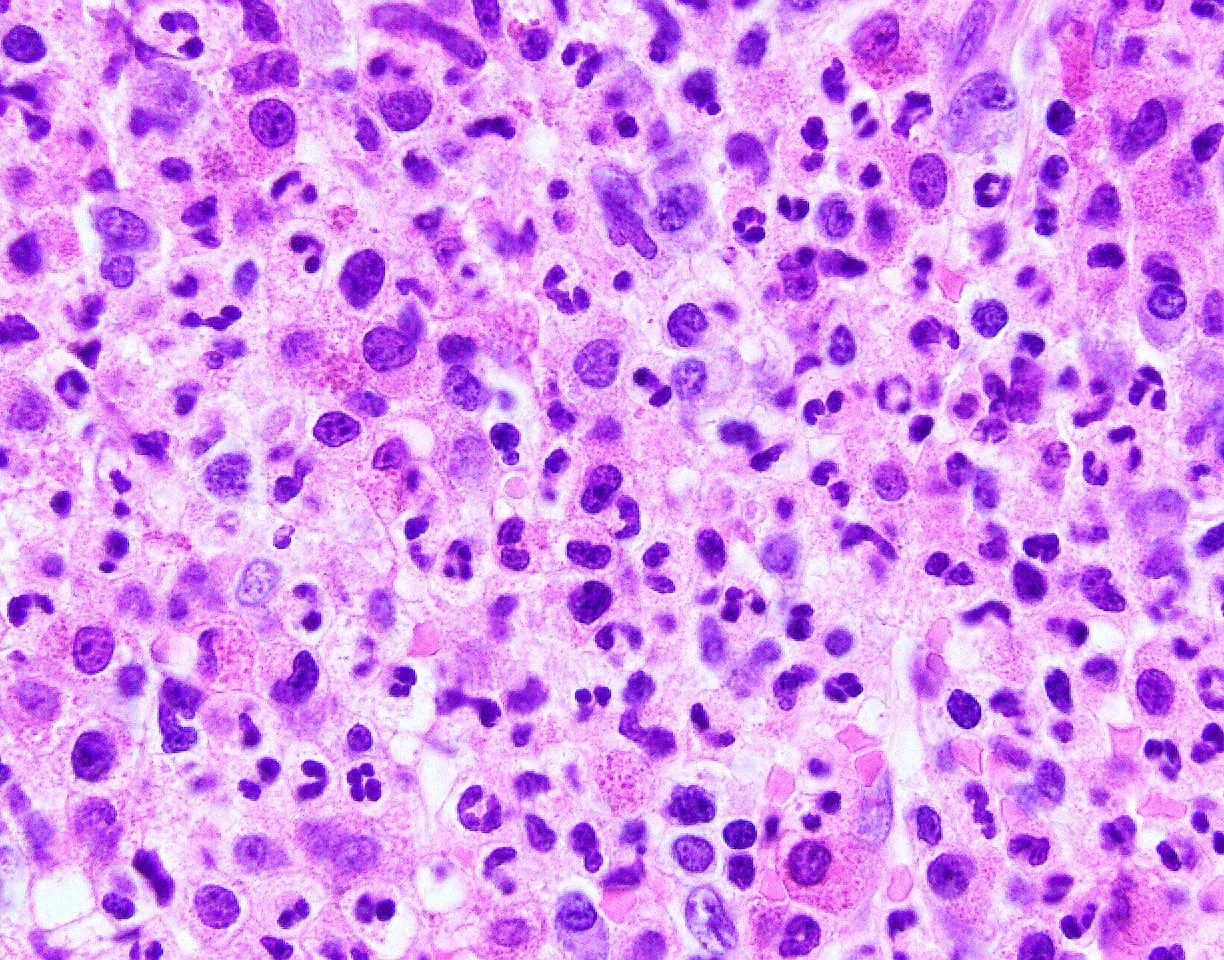

Table of Contents
Definition / general | Essential features | ICD coding | Epidemiology | Sites | Pathophysiology | Etiology | Clinical features | Diagnosis | Laboratory | Prognostic factors | Case reports | Treatment | Microscopic (histologic) description | Microscopic (histologic) images | Peripheral smear description | Peripheral smear images | Molecular / cytogenetics description | Sample pathology report | Differential diagnosis | Additional references | Board review style question #1 | Board review style answer #1 | Board review style question #2 | Board review style answer #2Cite this page: Li J, Shanmugam V. Chronic neutrophilic leukemia. PathologyOutlines.com website. https://www.pathologyoutlines.com/topic/myeloproliferativeCNL.html. Accessed April 19th, 2024.
Definition / general
- Rare myeloproliferative neoplasm characterized by persistent peripheral blood neutrophilia, bone marrow hypercellularity and hepatosplenomegaly
- Requires exclusion of reactive neutrophilia as well as other myeloproliferative neoplasms such as chronic myeloid leukemia (including typical, atypical and neutrophilic variants), polycythemia vera, primary myelofibrosis or myelodysplastic / myeloproliferative neoplasm
Essential features
- Persistent blood neutrophilia (≥ 25 x 109/L); with neutrophil ≥ 80% and myeloid precursors (promyelocytes, myelocytes and metamyelocytes) comprising < 10% of the white blood cells in peripheral blood
- Hypercellular bone marrow with predominance of neutrophilic granulocytes and blasts < 5%
- No dysgranulopoiesis
- CSF3R activating mutations are common
- Lacks BCR-ABL1 gene rearrangement, which distinguishes CNL from the neutrophilic variant of chronic myeloid leukemia
- Must be distinguished from reactive leukemoid reactions that can be seen in association with infectious or inflammatory processes or as a paraneoplastic phenomenon secondary to plasma cell neoplasms, lymphomas and some carcinomas
ICD coding
- ICD-10: D47.1 - Chronic myeloproliferative disease; also applicable to myeloproliferative disease, unspecified
Epidemiology
- Predominantly seen in older patients, with median age 66.5 years at diagnosis (range: 15 - 86) (Leukemia 2005;19:313)
- Slight male predominance (M:F = 1.6:1) (Br J Haematol 2015;171:400)
Sites
- Peripheral blood
- Bone marrow
- Spleen
- Liver
Pathophysiology
- CSF3R activating mutations identified in 89% of cases (N Engl J Med 2013;368:1781)
- Constitutional CSF3R T618I mutation in familial CNL (Blood 2016;128:2097, Br J Haematol 1999;105:428)
Etiology
- Unknown
- Some cases are associated with cytotoxic chemotherapy (Br J Haematol 2005;128:275)
- Substantial number of reported cases are associated with plasma cell neoplasm; these cases likely represent a neutrophilic leukemoid reaction secondary to production of G-CSF by neoplastic plasma cells (Br J Haematol 2015;171:400)
Clinical features
- Most consistent clinical feature is splenomegaly, which may be symptomatic (Cureus 2021;13:e15433, Clin Adv Hematol Oncol 2021;19:450)
- Other findings include hepatomegaly, fatigue, pruritus, easy bruising, purpura and bone pain
Diagnosis
- World Health Organization (WHO) 2016 revised diagnostic criteria:
- Peripheral blood white blood cell count ≥ 25 x 109/L
- Segmented neutrophils plus bands neutrophils constitute ≥ 80% of the white blood cells
- Neutrophil precursors (promyelocytes, myelocytes and metamyelocytes) constitute < 10% of the white blood cells
- Myeloblasts rarely if ever observed
- Monocyte count < 1 x 109/L
- No dysgranulopoiesis
- Hypercellular bone marrow
- Neutrophilic granulocytes increased in percentage and number
- Neutrophil maturation appears normal
- Myeloblasts constitute < 5% of the nucleated cells
- Not meeting WHO criteria for BCR-ABL1 positive chronic myeloid leukemia, polycythemia vera, essential thrombocythemia or primary myelofibrosis
- No rearrangement of PDGFRA, PDGFRB or FGFR1 and no PCM1-JAK2 fusion
- CSF3R T618I or another activating CSF3R mutation or persistent neutrophilia (≥ 3 months), splenomegaly and no identifiable cause of reactive neutrophilia including absence of a plasma cell neoplasm or if a plasma cell neoplasm is present, demonstration of clonality of myeloid cells by cytogenetic or molecular studies (Pathology 2021;53:339)
- Peripheral blood white blood cell count ≥ 25 x 109/L
Laboratory
- Persistent mature neutrophilia
- Absence of monocytosis, basophilia, eosinophilia or increased immature myeloid cells
- Majority of patients present with mild anemia (Leukemia 2005;19:313)
- Elevated lactate dehydrogenase (LDH) and leukocyte alkaline phosphatase (LAP)
- Elevated vitamin B12 and uric acid
Prognostic factors
- Median overall survival after diagnosis, approximately 1.8 years (Curr Treat Options Oncol 2021;22:59)
- Transformation to acute myeloid leukemia can occur (Curr Hematol Rep 2004;3:210, Ann Hematol 2021;100:1459, Blood Adv 2020;4:5389)
- CSF3R T618I mutated CNL has worse prognosis compared with CNL with other CSF3R activating mutations (Blood Cancer J 2018;8:21)
- Coexistence of CSF3R and ASXL1 mutations is associated with a worse prognosis (Am J Hematol 2015;90:653)
- Risk model for CSF3R mutated CNL (Blood Cancer J 2018;8:21)
- Low risk (0 - 1 point) versus high risk (2 - 4 points) groups, based on the following criteria:
- Platelets < 160 x 109/L (2 points)
- Leukocytes > 60 x 109/L (1 point)
- ASXL1 mutation (1 point)
- Low risk (0 - 1 point) versus high risk (2 - 4 points) groups, based on the following criteria:
Case reports
- 18 year old man with abdominal pain, splenomegaly and unexplained leukocytosis (Blood 2019;134:2414)
- 65 year old woman patient who presented with leukocytosis (BMC Cancer 2018;18:343)
- 70 year old woman presented with pain in the right great toe and ankle (Indian J Cancer 2020;57:201)
- 78 year old man presented with leukocytosis (Oncol Lett 2015;9:2208)
- 80 year old man with 1 month of fatigue (World J Clin Cases 2020;8:6337)
Treatment
- Hydroxyurea: most commonly used agent, with most patients showing an initial response (Leukemia 2005;19:313)
- Most patients will require second or third line agents (Blood Cancer J 2018;8:21):
- Interferon alpha
- Ruxolitinib
- Thalidomide
- Cladribine
- Imatinib
- Hematopoietic stem cell transplantation is the only potentially curative therapy (Curr Treat Options Oncol 2021;22:59)
Microscopic (histologic) description
- Hypercellular bone marrow with increased myeloid to erythroid ratio; up to 20:1
- Increase in neutrophilic granulocytes
- Myeloblasts and promyelocytes are not increased
- No dysplasia in erythroid and myeloid series or megakaryocytes
- Spleen with leukemic neutrophilic infiltrate in the red pulp
- Liver with mature leukemic granulocytes in sinusoids or portal spaces
Microscopic (histologic) images
Peripheral smear description
- Peripheral blood with neutrophilia, including mature neutrophils and bands
- Toxic granulation and Döhle bodies in neutrophils
Peripheral smear images
Molecular / cytogenetics description
- CSF3R mutations, up to 89% in a case series (N Engl J Med 2013;368:1781)
- Can associate with ASXL1 or SETBP1 mutations
- JAK2 V617F can also be observed
- Cytogenetic studies are normal in 90% of cases
- Remaining cases show:
- Gains of chromosomes 8, 9 and 21
- del(7q), del(11q), del(12p) and del(20q)
- Nullisomy 17
- Absence of BCR-ABL1 rearrangement
- Absence of rearrangements in PDGFRA, PDGFRB, FGRF1 or PCM1-JAK2
Sample pathology report
- Bone marrow core biopsy and clot specimen, aspirate smears and peripheral blood:
- Chronic neutrophilic leukemia, 1% blasts (see comment)
- Comment:
- The bone marrow core biopsy is adequate in size and quality. The marrow is markedly cellular (> 95% cellular). Erythroid precursors are decreased and exhibit adequate maturation. Myeloid cells are markedly increased and exhibit maturation. Megakaryocytes are present in normal number and morphologically are unremarkable. Scattered mast cells are seen and do not form aggregates. Scattered lymphocytes and plasma cells are seen. Lymphoid aggregates are not identified. Bone trabeculae exhibit focal osteoblastic activity with no osteosclerosis.
- Reticulin stain shows no significant reticulin fibrosis. Trichrome stain shows no abnormal collagen fibrosis.
- Immunohistochemistry for CD34 reveals that less than 5% of marrow cells are positive. In situ hybridization for kappa and lambda immunoglobulin light chains demonstrate polytypic expression in the plasma cells.
- Bone marrow aspirate smears show a cell differential with blasts 1%, promyelocytes 2%, myelocytes 2%, metamyelocytes 2%, and granulocytes and bands aggregate to 82%; lymphocytes 3%, plasma cells 2% and erythroid precursors 4%. The myeloid to erythroid ratio is 23 (91:4).
- FISH assays did not show rearrangements of PDGFRA, PDGFRB, FGFR1 or BCR-ABL1.
- Next generation sequencing showed the following findings: Pathogenic single nucleotide variants and small insertions / deletions:
- ASXL1 NM_015338 c.1534C>T p.Q512* - in 46.6% of 1104 reads
- CSF3R NM_156039 c.1853C>T p.T618I - in 41.2% of 699 reads
- Read count analysis shows gain of JAK2 (on 9p).
- FLT3 ITD is not detected.
- Comment: The findings are of a hypercellular marrow with myeloid hyperplasia with no significant fibrosis or increase in blasts. No significant dysplasia is noted on the aspirate smear. Next generation sequencing using probes for 81 gene mutations associated with myeloid neoplasms demonstrated a canonical CSF3R (T618I) mutation along with pathogenic ASXL1 mutations. FISH analysis did not show rearrangements involving PDGFRA, PDGFRB, FGFR1 or BCR-ABL1.
- The diagnosis of chronic neutrophilic leukemia is rendered based on the presence of persistent neutrophilia (69.78 x 109/L neutrophils, immature myeloid cells < 10%) and CSF3R mutation.
Differential diagnosis
- Chronic myeloid leukemia (CML):
- Associated with BCR-ABL1 fusion gene, frequent basophilia, thrombocytosis or eosinophilia
- Neutrophilic chronic myeloid leukemia (N-CML):
- Uncommon BCR-ABL1 fusion that results in a 230 kD fusion protein (p230)
- Atypical CML:
- Prominent granulocytic dysplasia and left shift
- Chronic myelomonocytic leukemia (CMML):
- Chronic monocytosis (> 1 x 109/L) and dysplasia
- Leukemoid reaction / infection:
- Rule out underlying infection or other malignancies (plasma cell neoplasms and others)
- Lacks CSF3R mutations or other cytogenetic abnormalities seen in CNL listed above in the molecular / cytogenetics section
Additional references
Board review style question #1
A 53 year old man presents with abdominal pain. Abdominal imaging shows splenomegaly and a CBC shows leukocytosis (70 x 109/L) with 95% neutrophils. A representative image of the bone marrow biopsy is shown below. An extensive laboratory work up is negative for infection or other causes that could explain these findings. Molecular studies do not reveal a BCR-ABL rearrangement. What is the gene that is most commonly mutated in this condition?
- CSF3R
- JAK2
- NOTCH2
- RUNX1
- TET2
Board review style answer #1
A. CSF3R, which is the gene that is most frequently mutated in chronic neutrophilic leukemia. JAK2 mutations are most frequent in polycythemia vera. NOTCH2 mutations are more frequent in B cell lymphomas (splenic marginal zone lymphoma, diffuse large B cell lymphoma). RUNX1 mutations are seen in other myeloid neoplasms (acute myeloid leukemia, myelodysplastic syndrome) but are uncommon in myeloproliferative neoplasms. TET2 mutations are frequent in a variety of myeloid neoplasms and are not specific to any particular class.
Comment Here
Reference: Chronic neutrophilic leukemia
Comment Here
Reference: Chronic neutrophilic leukemia
Board review style question #2
Which of the following features distinguishes chronic neutrophilic leukemia (CNL) from atypical chronic myeloid leukemia, BCR-ABL1 negative?
- Lack of basophilia in CNL
- Lack of dysgranulopoiesis in CNL
- Lack of monocytosis in CNL
- Presence of ASXL1 mutation in CNL
- WBC count > 50 x 109/L
Board review style answer #2
B. Lack of dysgranulopoiesis. Granulocytic dysplasia is not seen in chronic neutrophilic leukemia, while it is a typical feature of atypical CML.
Comment Here
Reference: Chronic neutrophilic leukemia
Comment Here
Reference: Chronic neutrophilic leukemia